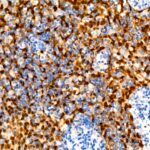

CDKN2A/p16INK4a Mouse mAb (A18219)
$148.00 – $660.00
Abclonal CDKN2A/p16INK4a Mouse mAb (Catalog Number: A18219) generates several transcript variants which differ in their first exons. At least three alternatively spliced variants encoding distinct proteins have been reported, two of which encode structurally related isoforms known to function as inhibitors of CDK4 kinase.
- Details & Specifications
- References
| Catalog No. | A18219 |
|---|---|
| Product Name | CDKN2A/p16INK4a Mouse mAb (A18219) |
| Supplier Name | ABclonal, Inc. |
| Brand Name | Abclonal |
| Synonyms | ARF; MLM; P14; P16; P19; CMM2; INK4; MTS1; TP16; CDK4I; CDKN2; INK4A; MTS-1; P14ARF; P19ARF; P16INK4; P16INK4A; P16-INK4A |
| Gene Name | CDKN2A |
| Protein Name | CDKN2A |
| Uniprot/Swissprot ID | P42771/Q8N726 |
| Gene ID | 1029 |
| Clone | AMC0529 |
| Clonality | Monoclonal |
| Source/Host | Mouse |
| Reactivity | Human |
| Conjugate | Unconjugated |
| Note | Products will be shipped from the warehouse in Massachusetts. Promotion is running from time to time. Welcome to send a request for quote to message@sydlabs.com. |
| Order Offline | Syd Labs, Inc. 4 Avenue E, Hopkinton, MA 01748 USA. Phone: 1-617-401-8149 Fax: 1-617-606-5019 Email: message@sydlabs.com |
Description
A18219: CDKN2A/p16INK4a Mouse mAb
This gene generates several transcript variants which differ in their first exons. At least three alternatively spliced variants encoding distinct proteins have been reported, two of which encode structurally related isoforms known to function as inhibitors of CDK4 kinase. The remaining transcript includes an alternate first exon located 20 Kb upstream of the remainder of the gene; this transcript contains an alternate open reading frame (ARF) that specifies a protein which is structurally unrelated to the products of the other variants. This ARF product functions as a stabilizer of the tumor suppressor protein p53 as it can interact with, and sequester, the E3 ubiquitin-protein ligase MDM2, a protein responsible for the degradation of p53. In spite of the structural and functional differences, the CDK inhibitor isoforms and the ARF product encoded by this gene, through the regulatory roles of CDK4 and p53 in cell cycle G1 progression, share a common functionality in cell cycle G1 control. This gene is frequently mutated or deleted in a wide variety of tumors, and is known to be an important tumor suppressor gene.
Immunogen Information about CDKN2A/p16INK4a Mouse mAb (A18219)
Immunogen:Recombinant protein of human CDKN2A/p16INK4a.
Sequence:
Gene ID:1029
Swiss prot:P42771 Q8N726
Synonyms:ARF; MLM; P14; P16; P19; CMM2; INK4; MTS1; TP16; CDK4I; CDKN2; INK4A; MTS-1; P14ARF; P19ARF; P16INK4; P16INK4A; P16-INK4A; CDKN2A/p16INK4a
Calculated MW:8kDa/11kDa/12kDa/13kDa/16kDa/17kDa
Observed MW:16kDa
Images of CDKN2A/p16INK4a Mouse mAb (A18219)

Western blot analysis of various lysates using CDKN2A/p16INK4a Mouse mAb (A18219) at 1:1000 dilution.
Secondary antibody: HRP Goat Anti-Mouse IgG (H+L) (AS003) at 1:10000 dilution.
Lysates/proteins: 25μg per lane.
Blocking buffer: 3% nonfat dry milk in TBST.
Detection: ECL Basic Kit (RM00020).
Exposure time: 60s.

Immunohistochemistry analysis of CDKN2A/p16INK4a in paraffin-embedded human cervix cancer using CDKN2A/p16INK4a Mouse mAb (A18219) at dilution of 1:100 (40x lens).Perform high pressure antigen retrieval with 10 mM Tris/EDTA buffer pH 9.0 before commencing with IHC staining protocol.
Please remember our product information: CDKN2A/p16INK4a Mouse mAb (Catalog Number: A18219) Abclonal